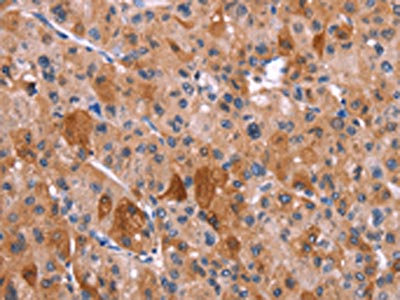
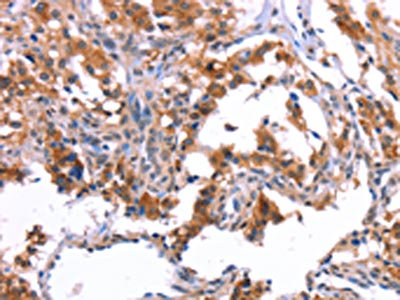

HRH1 Antibody
-
中文名稱:HRH1兔多克隆抗體
-
貨號:CSB-PA334654
-
規(guī)格:¥1100
-
圖片:
-
The image on the left is immunohistochemistry of paraffin-embedded Human liver cancer tissue using CSB-PA334654(HRH1 Antibody) at dilution 1/40, on the right is treated with synthetic peptide. (Original magnification: ×200)
-
The image on the left is immunohistochemistry of paraffin-embedded Human thyroid cancer tissue using CSB-PA334654(HRH1 Antibody) at dilution 1/40, on the right is treated with synthetic peptide. (Original magnification: ×200)
-
-
其他:
產(chǎn)品詳情
-
Uniprot No.:
-
基因名:
-
別名:BPHS, mouse, homolog of antibody; H1 R antibody; H1R antibody; HH1R antibody; HisH1 antibody; Histamine H(1) receptor antibody; Histamine H1 receptor antibody; Histamine receptor H1 antibody; Histamine receptor subclass H1 antibody; Hrh1 antibody; HRH1_HUMAN antibody
-
宿主:Rabbit
-
反應(yīng)種屬:Human
-
免疫原:Synthetic peptide of Human HRH1
-
免疫原種屬:Homo sapiens (Human)
-
標(biāo)記方式:Non-conjugated
-
抗體亞型:IgG
-
純化方式:Antigen affinity purification
-
濃度:It differs from different batches. Please contact us to confirm it.
-
保存緩沖液:-20°C, pH7.4 PBS, 0.05% NaN3, 40% Glycerol
-
產(chǎn)品提供形式:Liquid
-
應(yīng)用范圍:ELISA,IHC
-
推薦稀釋比:
Application Recommended Dilution ELISA 1:1000-1:2000 IHC 1:25-1:100 -
Protocols:
-
儲存條件:Upon receipt, store at -20°C or -80°C. Avoid repeated freeze.
-
貨期:Basically, we can dispatch the products out in 1-3 working days after receiving your orders. Delivery time maybe differs from different purchasing way or location, please kindly consult your local distributors for specific delivery time.
-
用途:For Research Use Only. Not for use in diagnostic or therapeutic procedures.
相關(guān)產(chǎn)品
靶點(diǎn)詳情
-
功能:In peripheral tissues, the H1 subclass of histamine receptors mediates the contraction of smooth muscles, increase in capillary permeability due to contraction of terminal venules, and catecholamine release from adrenal medulla, as well as mediating neurotransmission in the central nervous system.
-
基因功能參考文獻(xiàn):
- H1R and H4R are useful biomarkers of allergic inflammation on the ocular surface. Most notably, H4R expressed on eosinophils is useful as a biomarker of eosinophilic inflammation of the ocular surface. PMID: 28391980
- This study demonstrated that HRH1 gene polymorphisms associated with sedation in clozapine-treated patient with schizophrenia. PMID: 28400155
- Human H1 receptors in Chinese hamster ovary cells are apparently down-regulated by a sustained increase in intracellular Ca(2+) concentrations with no process of endocytosis and lysosomal/proteasomal degradation of receptors. PMID: 29063596
- Antihistamines displayed similar kinetic signatures on antagonizing histamine-induced beta-arrestin2 recruitment as compared to displacing radioligand binding from the H1R. PMID: 27468652
- Study suggests that both MAPK p44/p42 and PKC pathways appear to be involved in histamine-upregulated matrix metalloproteinase-9 release via histamine H1 receptors in astrocytes. PMID: 25682263
- that histamine H1 receptor activation mediates MAPK activation through PLCbeta, Src, PKCdelta and MEK pathway, but does not lead to nuclear relocalization of phospho-ERK (pERK), classically associated with pro-proliferative changes. PMID: 27871651
- Activation of the H1R by its full agonists resulted in a composite potentiating effect. Intriguingly, inactivation of the Gaq-PLC pathway by H1R inverse agonists resulted also in a potentiation of GR activity. PMID: 26635083
- HRH1-mediated sensitization of TRPV1 is involved in IBS. Ebastine, an antagonist of HRH1, reduced visceral hypersensitivity, symptoms, and abdominal pain in patients with IBS. PMID: 26752109
- multiple signaling pathways contribute to histamine-induced endothelial barrier dysfunction via the H1 receptor. PMID: 25582918
- Thus, the results in the initial study were due to the degradation of histamine in skeletal muscle by ascorbate, because the histaminergic vasodilatation was unaffected by N-acetylcysteine. PMID: 25664905
- HRH1 transcript was significantly down-modulated in multiple sclerose compared with health control. PMID: 25293806
- The relationship between the expression of HRH1 and prognosis was found to vary in different types of cancers, even in the same cancer from different databases. PMID: 24535227
- But carriers of one or three copies of HRH1 (5% of individuals), HRH2 (1.1%) and HRH4 genes (0.9%) were also identified. PMID: 24236486
- Overexpression of H1R further increases the oxidative output of Duox-expressing HEK-293 cells. PMID: 23962049
- Histamine demonstrably inhibited ACh-induced sweating in both mice and humans via H1R-mediated signaling. PMID: 23900020
- our study does not support the contribution of histamine H1HR gene variants to antipsychotic induced weight gain nor differences in distribution between healthy volunteers and patients with schizophrenia PMID: 23609395
- In this review, we focus on the role of histamine and its receptors in the treatment of Alzheimer's disease. PMID: 23677734
- Our observations point to a close histamine-/HR-mediated activation of dermal macrophages, leading to modified cell differentiation and responsiveness via H1R, which might contribute to the aggravation of allergic skin inflammation in AD. PMID: 23414213
- Histamine was able to synergistically augment bFGF-induced angiogenesis, and this action was linked to VEGF production through H1-receptor. PMID: 23225320
- [review] The H1, H2, and H3 receptors are all involved in recovery of neurological function when extracellular histamine is gradually increasing, after cerebral ischemia. PMID: 22860191
- Study revealed that epithelial cells and vascular endothelial cells showed intense immunoreactivity for histamine H1 receptor inperennial allergic rhinitis. PMID: 23132961
- The glu349asp polymorphism of histamine-1 receptor is not associated with antipsychotic induced weight gain. PMID: 21937795
- evidence supports the involvement of histaminergic and gamma-aminobutyric acidergic mechanisms in the etiology of TS and show an overlap of rare CNVs in TS and autism spectrum disorder. PMID: 22169095
- Measurement of H1R occupancy is a sensitive and absolute method to characterize the non-sedating property of drugs with H1 antagonistic activity. PMID: 21433074
- the PKCdelta/ERK/poly(ADP-ribose) polymerase-1 signaling pathway is involved in histamine- or PMA-induced up-regulation of H1R gene expression in HeLa cells PMID: 21730054
- H1 and PAR2 receptors enhance delivery of immune-competent cells and molecules by interrupting E-cadherin adhesion in lung epithelial cells. PMID: 21686228
- crystal structure of the H(1)R complex with doxepin, a first-generation H(1)R antagonist PMID: 21697825
- Results demonstrate that LPS, through TLR4 activation, up-regulates the expression and function of H1R and amplifies histamine-induced inflammatory responses in HCAEC. PMID: 21255012
- Functional coupling of the H1R to Gq-PLC leads to the activation of RhoA and Rac small GTPases and suggest distinct roles for Rho GTPases in the control of cell proliferation by histamine. PMID: 19913013
- could be detected at the feto-maternal interface of human PMID: 11603849
- expressed on monocyte-derived dendritic cells PMID: 11898002
- genetic variant of this protein and body weight change during clozapine treatment in schizophrenia PMID: 12218662
- markedly different potency for activation of multiple signaling pathways by H1- and H2-HRs PMID: 12680587
- there are three mechanisms for h1 receptor down regulation: phosphorylation of thr-140 or ser-398 or five sites PMID: 12755404
- No significant differences in H1R or H2R mRNA levels between seasonal allergic rhinitic and nonrhinitic subjects in-season, despite observed differences in H reactivity. PMID: 12757445
- Thr140 and Ser398 mainly contributed to downregulation, and Thr142 or Ser396 had a slight inhibitory effect on Thr140- or Ser398-mediated process, respectively PMID: 15328002
- rapid termination of H1HR signaling is mediated by both the kinase activity and RGS function of GRK2 PMID: 15542600
- expression of the histamine (H) receptors 1 (H1) and 2 (H2) by germinal, interstitial, and peritubular cells in the testes of fertile and infertile patients PMID: 15820830
- gene expression regulation of HRH1 gene by HRH1 PMID: 15928828
- expression in chondrocytes of osteoarthritic cartilage PMID: 15928843
- analysis of agonist binding to histamine H(1) receptor PMID: 16027157
- characterization of important steps in the activation of the human histamine H1 receptor PMID: 16408006
- These data suggest the use of alternative promoters directing human H1 receptor gene expression, both within and between cell types. PMID: 16484687
- The H1R-PKC-ERK pathway may play crucial roles in eliciting cytokine production from bronchial epithelial cells stimulated by histamine, leading to airway inflammation PMID: 16491014
- results exclude the participation of histamine receptors other than the H1 subtype in the control of human intestinal motility by oxogenous histamine PMID: 16547808
- histamine stimulates integrin alpha-V beta-3 expression in cultured trophoblast cells; the H1 receptor is implicated PMID: 16705383
- Ascorbate enhancement of seven-transmembrane-spanning membrane receptor activity occurs in both adrenergic and histaminergic receptors. These receptors may play a significant role in maintaining extracellular ascorbate in a reduced state. PMID: 16760260
- These data suggest postexercise skeletal muscle hyperemia exists in endurance trained men and women. PMID: 16888049
- Histamine stimulates IL-6 release from SW982 cells by binding to the H1 receptor and this is coupled to the PI/PKC signal transduction pathway. PMID: 17122961
- The data suggest a global functional analogy between H1 receptor activation and the meta I/meta II charge/discharge equilibrium in rhodopsin. PMID: 17243823
顯示更多
收起更多
-
亞細(xì)胞定位:Cell membrane; Multi-pass membrane protein.
-
蛋白家族:G-protein coupled receptor 1 family
-
數(shù)據(jù)庫鏈接:
Most popular with customers
-
-
YWHAB Recombinant Monoclonal Antibody
Applications: ELISA, WB, IHC, IF, FC
Species Reactivity: Human, Mouse, Rat
-
Phospho-YAP1 (S127) Recombinant Monoclonal Antibody
Applications: ELISA, WB, IHC
Species Reactivity: Human
-
-
-
-
-